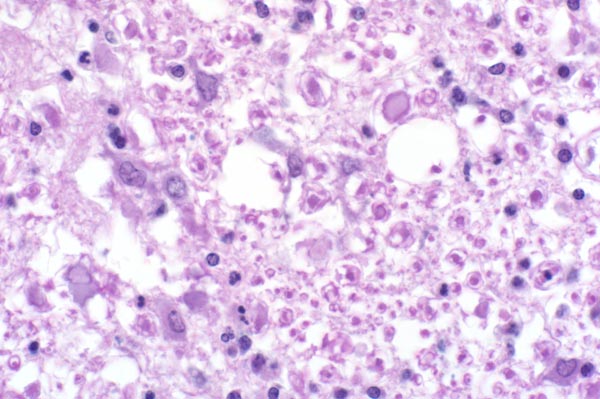

| 40x | Hematoxylin and Eosin | ||||
| Close Window | Macro View | Show Help | Back | |
|
Axons are swollen (spheroids) (arrow) and myelin sheaths are dilated and often contain gitter cells (arrowhead). Few astrocytes have expanded, amphophilic cytoplasm (gemistocytes) (G).
|
||||

|
||||
| Return | ||||
|
Axons are swollen (spheroids) (arrow) and myelin sheaths are dilated and often contain gitter cells (arrowhead). Few astrocytes have expanded, amphophilic cytoplasm (gemistocytes) (G).
|
||||